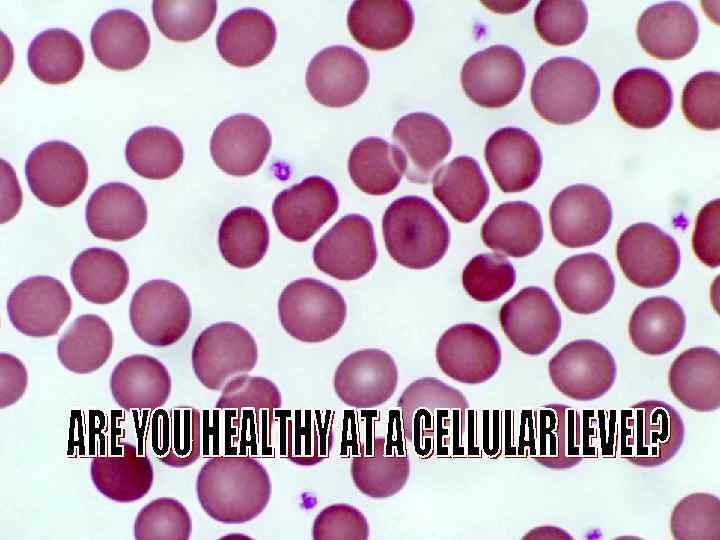

What does GOOD HEALTH really mean ?
What does GOOD HEALTH really mean ?
 WHO Facts & Figure - Current Health Scenario • India currently has 50. 8 million world's largest Diabetes population. Diabetic patients, India has the • 60% People die due to coronary Artery Disease world wide. • Around 7. 9 million people died of cancer in 2007 world wide, and 2015 it will be 84 million. • The estimated number of new cancers in India per year is about 7 lakhs and over 3. 5 lakhs people die of cancer each year. Out of these 7 lakhs new cancers about 2. 3 lakhs (33%) cancers are tobacco related. • 84. 79% Urban Indians have medical disorders without an identifiable organic cause and with high level of STRESS and TENSION.
WHO Facts & Figure - Current Health Scenario • India currently has 50. 8 million world's largest Diabetes population. Diabetic patients, India has the • 60% People die due to coronary Artery Disease world wide. • Around 7. 9 million people died of cancer in 2007 world wide, and 2015 it will be 84 million. • The estimated number of new cancers in India per year is about 7 lakhs and over 3. 5 lakhs people die of cancer each year. Out of these 7 lakhs new cancers about 2. 3 lakhs (33%) cancers are tobacco related. • 84. 79% Urban Indians have medical disorders without an identifiable organic cause and with high level of STRESS and TENSION.
 So how healthy are WE… ?
So how healthy are WE… ?
What is the role of water in maintaining our GOOD HEALTH
What is the role of water in maintaining our GOOD HEALTH
 Some facts … • Human body = 75% (Water) • Human brain = 85% • Human blood = 95% • Ulcer pains, colitis, acidosis or severe constipation are clear indications of lack of proper hydration. • By maintaining the optimum p. H balance in our digestive system we will enjoy far better levels of health and energy.
Some facts … • Human body = 75% (Water) • Human brain = 85% • Human blood = 95% • Ulcer pains, colitis, acidosis or severe constipation are clear indications of lack of proper hydration. • By maintaining the optimum p. H balance in our digestive system we will enjoy far better levels of health and energy.
 p. H & Health • What is p. H? • p. H stands for the Power of Hydrogen. The p. H measures the action of hydrogen and the balance of acidity and alkalinity in the living system. • According to many health researchers, total healing of chronic illness takes place only when and if the blood is restored to a normal, slightly alkaline p. H between 7. 35 to 7. 45. • Mild Acidosis may cause below complications: - Weight gain, obesity and diabetes. -Bladder and kidney conditions, including kidney stones. - Acceleration of free radical damage, possibly contributing to cancerous mutations. - Premature aging. - Osteoporosis; weak, brittle bones, hip fractures and bone spurs. - Joint pain, aching muscles and lactic acid build-up. -Low energy and chronic fatigue. • A healthy diet should consist of 80% alkaline-forming foods and 20% acid forming foods. !!!!Good News is that Bio water helps significantly in reducing acidity!!!!
p. H & Health • What is p. H? • p. H stands for the Power of Hydrogen. The p. H measures the action of hydrogen and the balance of acidity and alkalinity in the living system. • According to many health researchers, total healing of chronic illness takes place only when and if the blood is restored to a normal, slightly alkaline p. H between 7. 35 to 7. 45. • Mild Acidosis may cause below complications: - Weight gain, obesity and diabetes. -Bladder and kidney conditions, including kidney stones. - Acceleration of free radical damage, possibly contributing to cancerous mutations. - Premature aging. - Osteoporosis; weak, brittle bones, hip fractures and bone spurs. - Joint pain, aching muscles and lactic acid build-up. -Low energy and chronic fatigue. • A healthy diet should consist of 80% alkaline-forming foods and 20% acid forming foods. !!!!Good News is that Bio water helps significantly in reducing acidity!!!!
 Water & Disease : Research of Dr. Alex Carrel on Aging • Dr. Alexis Carrel, French scientist, had received the Nobel Prize in Medicine for keeping the cells of a chicken heart alive for 34 years. • Dr. Carrel said that 'The cell is immortal by design. It is merely the fluid (water) in which it floats that degenerates. Renew this fluid at intervals, give the cells what they require for nutrition and, as far as we know, the pulsation of life may go on forever. " • Degeneration of tissues or Cells cause aging. Water is Life
Water & Disease : Research of Dr. Alex Carrel on Aging • Dr. Alexis Carrel, French scientist, had received the Nobel Prize in Medicine for keeping the cells of a chicken heart alive for 34 years. • Dr. Carrel said that 'The cell is immortal by design. It is merely the fluid (water) in which it floats that degenerates. Renew this fluid at intervals, give the cells what they require for nutrition and, as far as we know, the pulsation of life may go on forever. " • Degeneration of tissues or Cells cause aging. Water is Life
 What is the best form of water ? Natural Spring water
What is the best form of water ? Natural Spring water
 Ultimate Water • Water that last long. • Water that keep us young. • Water that keep us healthy. • Refresh us when we take bath. • Keep us free from diseases. • Help us living long life. • Full of Minerals. • Water that taste great. -Hunza, in the Karakorum Mountains in Po. K, which is famous for the people's longevity is indeed related to the water that they drank. In Hunza people maintain their vitality beyond 100 years. - Ganga water is also one of the famous water in the world, The bacterium Vibrio Cholerae which causes the deadly Cholera disease, when put into the waters of Ganga died within three hours! The same bacteria continued to thrive in distilled water even after 48 hours! - Water sources in Ecuador, Peru, the county of Georgia in Russia, Mongolia, Venezuela also have great magical stories. Quest began to understand create the Ultimate water for domestic use.
Ultimate Water • Water that last long. • Water that keep us young. • Water that keep us healthy. • Refresh us when we take bath. • Keep us free from diseases. • Help us living long life. • Full of Minerals. • Water that taste great. -Hunza, in the Karakorum Mountains in Po. K, which is famous for the people's longevity is indeed related to the water that they drank. In Hunza people maintain their vitality beyond 100 years. - Ganga water is also one of the famous water in the world, The bacterium Vibrio Cholerae which causes the deadly Cholera disease, when put into the waters of Ganga died within three hours! The same bacteria continued to thrive in distilled water even after 48 hours! - Water sources in Ecuador, Peru, the county of Georgia in Russia, Mongolia, Venezuela also have great magical stories. Quest began to understand create the Ultimate water for domestic use.
 Natural spring waters = Healing Water • • Spring water is the purest form of water The miracles of this water is simply astonishing Across the world there are 14 mountain springs Spring water is scientifically proven to contain healing qualities due to its higher content of Calcium and Magnesium Salts and also natural fluorides that encompass a germicidal action Basaltic Rocks Perfect Crystal Shape
Natural spring waters = Healing Water • • Spring water is the purest form of water The miracles of this water is simply astonishing Across the world there are 14 mountain springs Spring water is scientifically proven to contain healing qualities due to its higher content of Calcium and Magnesium Salts and also natural fluorides that encompass a germicidal action Basaltic Rocks Perfect Crystal Shape
 Natural Springs worldwide
Natural Springs worldwide
 Can we prepare ‘Structured water’ AT HOME ?
Can we prepare ‘Structured water’ AT HOME ?
 Thanks to the Bio Disc-2 Unlimited amount of Crystal water can be made at home Non-Treated Water Treated With Amezcua Bio Disc 2 "Given that our bodies are 70% water, using Nano technology gives our bodies a 70% better chance. We look younger, we're more energized, and at the end of the day, we're healthier!“’- Ian Lyons
Thanks to the Bio Disc-2 Unlimited amount of Crystal water can be made at home Non-Treated Water Treated With Amezcua Bio Disc 2 "Given that our bodies are 70% water, using Nano technology gives our bodies a 70% better chance. We look younger, we're more energized, and at the end of the day, we're healthier!“’- Ian Lyons
 Structured water • Bio treated water reduce the negative effects of Chlorine, Fluorides by locking it in to the quantum suspension within the molecular structure. Same is the case with cholesterol and oily foods. • The figure below is an example of a molecular cage made up of 20 water molecules. In water, minute cluster colloids exhibit a property known as "hydrophobic hydration". This occurs as water molecules form cage-like structures around suspended particles.
Structured water • Bio treated water reduce the negative effects of Chlorine, Fluorides by locking it in to the quantum suspension within the molecular structure. Same is the case with cholesterol and oily foods. • The figure below is an example of a molecular cage made up of 20 water molecules. In water, minute cluster colloids exhibit a property known as "hydrophobic hydration". This occurs as water molecules form cage-like structures around suspended particles.
 What is Bio Disc 2 made of ? • The Bio Disc is made of 14 Technically Engineered natural minerals • A Nano Fusion/High heat fusion process where the minerals structurally bonds together at a molecular level • The combination of the minerals and the fusion techniques produces a catalytic conversation of energy called: “Positive mineral energy” • Biodisc 2 emitts “BIO-PHOTONS”.
What is Bio Disc 2 made of ? • The Bio Disc is made of 14 Technically Engineered natural minerals • A Nano Fusion/High heat fusion process where the minerals structurally bonds together at a molecular level • The combination of the minerals and the fusion techniques produces a catalytic conversation of energy called: “Positive mineral energy” • Biodisc 2 emitts “BIO-PHOTONS”.
 Field of the BIODISC-2 resonance The BIODISC-2 Life Span is 15 yrs
Field of the BIODISC-2 resonance The BIODISC-2 Life Span is 15 yrs
 What are the current sources of our regular drinking water? • RESERVOIR • WATER DAM • BORE WELL ATTACHED TO MOTOR PUMP • TAP WATER • PIPE LINE SYSTEM IN METROS DISTORSION STRESS DEAD WATER
What are the current sources of our regular drinking water? • RESERVOIR • WATER DAM • BORE WELL ATTACHED TO MOTOR PUMP • TAP WATER • PIPE LINE SYSTEM IN METROS DISTORSION STRESS DEAD WATER
 Dead water vs. Structured water
Dead water vs. Structured water
 The above two images show vivified water differs from normal water. Beautiful water crystals are formed after exposure to the bio-disc as opposed to no crystals present in standard tap water. The picture on the left shows cells before drinking structured water and the picture on the right shows blood cells after absorbing structured water.
The above two images show vivified water differs from normal water. Beautiful water crystals are formed after exposure to the bio-disc as opposed to no crystals present in standard tap water. The picture on the left shows cells before drinking structured water and the picture on the right shows blood cells after absorbing structured water.
 • Blood Decongestion • Drinking Structured water bring blood cells to Zeta potential or make blood cells negatively charged. • This results in decongestion of the blood. • The picture on the left shows cells before drinking structured water and the picture on the right shows blood cells after absorbing structured water. Blood Cells before drinking structure water The image is of blood that was placed on a glass slide immediately after being sampled. (Notice the coining of the cells) Blood Cells after drinking structure water The image is of a quantity of the sample that was placed on a Bio. Disc for 20 minutes prior to microscopic examination. (Notice the cell separation)
• Blood Decongestion • Drinking Structured water bring blood cells to Zeta potential or make blood cells negatively charged. • This results in decongestion of the blood. • The picture on the left shows cells before drinking structured water and the picture on the right shows blood cells after absorbing structured water. Blood Cells before drinking structure water The image is of blood that was placed on a glass slide immediately after being sampled. (Notice the coining of the cells) Blood Cells after drinking structure water The image is of a quantity of the sample that was placed on a Bio. Disc for 20 minutes prior to microscopic examination. (Notice the cell separation)

 Structured water Lower Surface tension • Surface tension of Normal water is around 70 -80 Dynes/cm, Bio treatment of water brings it down to 50 Dynes/cm. • This makes water softer which improves hydration of the body and transfer the food nutrients easily which makes food more bio-available. Body Cell with Structured Water properly hydrated Body Cell with Unstructured Water Less hydrated • Better absorption of water detoxify the body, which improves immune system.
Structured water Lower Surface tension • Surface tension of Normal water is around 70 -80 Dynes/cm, Bio treatment of water brings it down to 50 Dynes/cm. • This makes water softer which improves hydration of the body and transfer the food nutrients easily which makes food more bio-available. Body Cell with Structured Water properly hydrated Body Cell with Unstructured Water Less hydrated • Better absorption of water detoxify the body, which improves immune system.
 Biowater – Dissolved Oxygen & PH Values
Biowater – Dissolved Oxygen & PH Values
 p. H change – Test done @ New Delhi Bio Disc: G 2 Room Temp : 25. 2 deg. C Digital p. H meter RO Water Bottle Mineral Water Time Charged p. H Temperature Deg C Before charging 6. 425 30. 2 Before charging 6. 640 16. 7 1 Time Charged 6. 560 28. 1 1 Time Charged 6. 590 16. 6 2 Time Charged 6. 775 26. 2 2 Time Charged 6. 685 16. 7 3 Time Charged 6. 846 25. 5 3 Time Charged 6. 730 17. 6 4 Time Charged 6. 970 24. 3 4 Time Charged 6. 780 18. 4 5 Time Charged 7. 075 23. 5 5 Time Charged 6. 845 19. 2 6 Time Charged 7. 145 22. 6 6 Time Charged 6. 960 19. 9
p. H change – Test done @ New Delhi Bio Disc: G 2 Room Temp : 25. 2 deg. C Digital p. H meter RO Water Bottle Mineral Water Time Charged p. H Temperature Deg C Before charging 6. 425 30. 2 Before charging 6. 640 16. 7 1 Time Charged 6. 560 28. 1 1 Time Charged 6. 590 16. 6 2 Time Charged 6. 775 26. 2 2 Time Charged 6. 685 16. 7 3 Time Charged 6. 846 25. 5 3 Time Charged 6. 730 17. 6 4 Time Charged 6. 970 24. 3 4 Time Charged 6. 780 18. 4 5 Time Charged 7. 075 23. 5 5 Time Charged 6. 845 19. 2 6 Time Charged 7. 145 22. 6 6 Time Charged 6. 960 19. 9
 Benefits of the Bio Disc 2 • Drinking water energizes • Maximizes Nutritional Benefits • Improves taste • Extends shelf life • Improves wellness • Enhances immune systems • Rejuvenates cells • Increase “BIO-PHOTONS” Exposes Positive Expels Negative
Benefits of the Bio Disc 2 • Drinking water energizes • Maximizes Nutritional Benefits • Improves taste • Extends shelf life • Improves wellness • Enhances immune systems • Rejuvenates cells • Increase “BIO-PHOTONS” Exposes Positive Expels Negative
 E-SMOG – Effect on Brain!!!!!!!
E-SMOG – Effect on Brain!!!!!!!
 Bio-photons –Biodisc 2 Bio photons are the ULTRAWEAK Light Radiations, coming from the Cells of ALL Living Entities. REDUCES Pain, Swelling, Inflammation & Irritation STIMULATES Healing Process STIMULATES Endorphins STIMULATES Serotonin Biophotns in a Leaf Responsible for intra- and intercellular communication and regulation with DNA as their fundamental source. Biophotns in a Human
Bio-photons –Biodisc 2 Bio photons are the ULTRAWEAK Light Radiations, coming from the Cells of ALL Living Entities. REDUCES Pain, Swelling, Inflammation & Irritation STIMULATES Healing Process STIMULATES Endorphins STIMULATES Serotonin Biophotns in a Leaf Responsible for intra- and intercellular communication and regulation with DNA as their fundamental source. Biophotns in a Human
 SIMPLE TESTS WITH THE BIO DISC 2 • Lemon Slice Test • Salt Taste test • Drinking Water Color, Purity and Taste • Cigarette test • Alcohol Test • Torch Light – Pain Relief Test • Vehicle Fuel Test • Moisturizer Test (Absorption Test) • Rose test (Shelf Life Extension) • Flexibility Test • Balance And Strength Test • Gravity Test
SIMPLE TESTS WITH THE BIO DISC 2 • Lemon Slice Test • Salt Taste test • Drinking Water Color, Purity and Taste • Cigarette test • Alcohol Test • Torch Light – Pain Relief Test • Vehicle Fuel Test • Moisturizer Test (Absorption Test) • Rose test (Shelf Life Extension) • Flexibility Test • Balance And Strength Test • Gravity Test


 CERTICATIONS AND EVALUATIONS
CERTICATIONS AND EVALUATIONS
 PROGNOS, Germany Tests run by the PROGNOS machine has shown that the Amezcua Bio Disc possesses a positive energy field. Results from the system have shown that after drinking water treated with the Amezcua Bio Disc, the tester’s energy levels has increased and disharmony of his meridian system is reduced. PROGNOS is a diagnostic and therapy system based on Traditional Medicine which uses a painless method to create a picture of the energetic state of the body. This is measured through the subject’s meridian system, or the energy courses of the human body. PROGNOS and its manufacturer Med. Prevent has been accredited with EC and ISO certifications by the EUROCAT Institute for Certification and Testing.
PROGNOS, Germany Tests run by the PROGNOS machine has shown that the Amezcua Bio Disc possesses a positive energy field. Results from the system have shown that after drinking water treated with the Amezcua Bio Disc, the tester’s energy levels has increased and disharmony of his meridian system is reduced. PROGNOS is a diagnostic and therapy system based on Traditional Medicine which uses a painless method to create a picture of the energetic state of the body. This is measured through the subject’s meridian system, or the energy courses of the human body. PROGNOS and its manufacturer Med. Prevent has been accredited with EC and ISO certifications by the EUROCAT Institute for Certification and Testing.
 PROGNOS Test Results from Bio Disc Treated Water Before drinking the treated water by the Bio Disc, the tester was test by a Prognos Machine to determine his health and shows that he lack of energy and disharmony of meridian system. After drinking the treated water, the tester was again tested by a Prognos Machine to determine his health and shows that his energy level has gone back to normal and disharmony or meridian system has also reduce from 48% to 34%. This shows the effect of after drinking the energized water.
PROGNOS Test Results from Bio Disc Treated Water Before drinking the treated water by the Bio Disc, the tester was test by a Prognos Machine to determine his health and shows that he lack of energy and disharmony of meridian system. After drinking the treated water, the tester was again tested by a Prognos Machine to determine his health and shows that his energy level has gone back to normal and disharmony or meridian system has also reduce from 48% to 34%. This shows the effect of after drinking the energized water.
 • Dr. med. Manfred Doepp is a member of the Board of the German Society for Energy and Information Medicine e. v. , Stuttgart.
• Dr. med. Manfred Doepp is a member of the Board of the German Society for Energy and Information Medicine e. v. , Stuttgart.
 WATER SURFACE TENSION RESULT PSB Laboratory - Singapore
WATER SURFACE TENSION RESULT PSB Laboratory - Singapore
 Dr. med Micheal Kucera • An internationally active medical doctor responsible for introducing the potential of Mitochondrial Medicine as a basic therapeutic tool • Monitors the efficacy of therapy by heart frequency variability measurement • Was awarded the international Mitochondrial Association (IMMA) Prize in 2000 An observational study shows that the Amezcua Bio Disc: • Reduces sympathetic activity of the nervous system, reducing tension, increasing reserves of stress adaptation capabilities, increasing parasympathetic activity and increasing energetic reserves • Has a harmonizing effect between sympathetic and parasympathetic parts of the autonomic nervous system • Improves regulatory and adaptation mechanisms
Dr. med Micheal Kucera • An internationally active medical doctor responsible for introducing the potential of Mitochondrial Medicine as a basic therapeutic tool • Monitors the efficacy of therapy by heart frequency variability measurement • Was awarded the international Mitochondrial Association (IMMA) Prize in 2000 An observational study shows that the Amezcua Bio Disc: • Reduces sympathetic activity of the nervous system, reducing tension, increasing reserves of stress adaptation capabilities, increasing parasympathetic activity and increasing energetic reserves • Has a harmonizing effect between sympathetic and parasympathetic parts of the autonomic nervous system • Improves regulatory and adaptation mechanisms

 Aura Analysis of Bio Water - Tests conducted by Centre for Biofieldsciences, Pune using POLYCONTRAST INTERFERENCE PHOTOGRAPHY (PIP) for the comparison between before and after scans. (www. biofieldsciences. com) - The energy field of tap water shows a pattern that has fair amount of low energy in the form of low frequency orange colour. A combination of green and violet is also seen. The energy field of Filter water shows equal distribution of green which is considered frequency of balance and orange that relates to low energies. Violet is associated with healing and it can be seen on the glass. - Bio disc water shows a lot of change in the energy field. Green has increased significantly. Low orange has reduced. Violet on the glass has considerably increased. Subsequently on day 2 we see more of violet. This is a very positive sign. Orange has absolutely disappeared. - On day 3 violet has become denser. Green can be seen over the glass.
Aura Analysis of Bio Water - Tests conducted by Centre for Biofieldsciences, Pune using POLYCONTRAST INTERFERENCE PHOTOGRAPHY (PIP) for the comparison between before and after scans. (www. biofieldsciences. com) - The energy field of tap water shows a pattern that has fair amount of low energy in the form of low frequency orange colour. A combination of green and violet is also seen. The energy field of Filter water shows equal distribution of green which is considered frequency of balance and orange that relates to low energies. Violet is associated with healing and it can be seen on the glass. - Bio disc water shows a lot of change in the energy field. Green has increased significantly. Low orange has reduced. Violet on the glass has considerably increased. Subsequently on day 2 we see more of violet. This is a very positive sign. Orange has absolutely disappeared. - On day 3 violet has become denser. Green can be seen over the glass.
 LIST OF EVALUATORS COUNTRY SCOPE I. H. M. Institute Japan Water crystal photography and energy levels in water Centre for Bio Field Sciences Pune, India Positive Effect Over Human Body & Balances Chakras and Energy Centres in Human Body The University of ITMO Russia Postive Effect on water & Human Body. Dr. med. Manfred Doepp Germany Energy levels in water and human body Dr. med Micheal Kussera Chez republic Reducing stress levels in human brain and heart with biowater. PSB Laboratory Singapore Water surface tension value PROGNOS, Med Prevent Germany Positive energy field SCHOTT AG Germany Manufacturer of bio disc glass
LIST OF EVALUATORS COUNTRY SCOPE I. H. M. Institute Japan Water crystal photography and energy levels in water Centre for Bio Field Sciences Pune, India Positive Effect Over Human Body & Balances Chakras and Energy Centres in Human Body The University of ITMO Russia Postive Effect on water & Human Body. Dr. med. Manfred Doepp Germany Energy levels in water and human body Dr. med Micheal Kussera Chez republic Reducing stress levels in human brain and heart with biowater. PSB Laboratory Singapore Water surface tension value PROGNOS, Med Prevent Germany Positive energy field SCHOTT AG Germany Manufacturer of bio disc glass

 WHERE HEALTH IS TRULY WEALTH
WHERE HEALTH IS TRULY WEALTH


